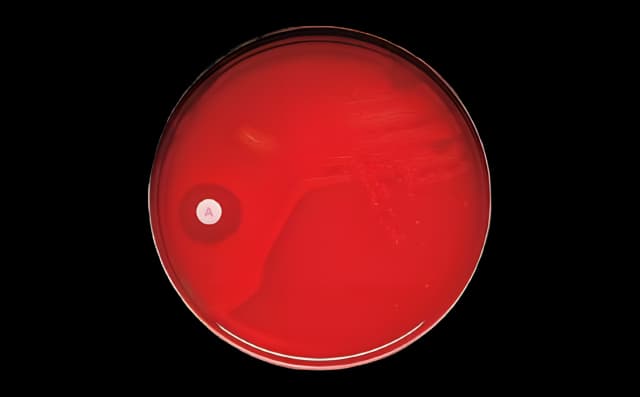
Differentiation Disc BBL™ Taxo™ A Bacitracin 0.04 U - 231041

Differentiation Disc BBL™ Taxo™ A Bacitracin 0.04 U - 231041
USAMP#48874311SKU: 231041BBL™ Taxo™ A

Product Spotlight
- Taxo™ A discs are for the presumptive identification of group A beta-hemolytic streptococci based on susceptibility to a low level of bacitracin
- A discs are impregnated with approximately 0.04 unit of bacitracin per disc